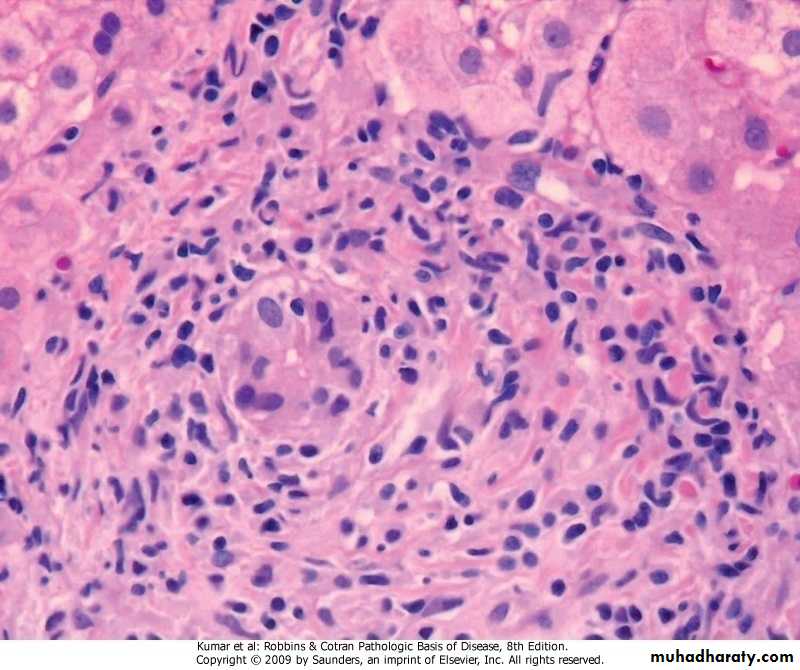

Metabolic Liver Diseases
NON-ALCOHOLIC FATTY LIVER DISEASE (NAFLD).simple hepatic steatosis.steatosis with minor inflammation -both are asymptomatic.non-alcoholic steatohepatitis (NASH) -hepatocyte injury>cirrhosis in 10%-20% -pathogenesis, genetics & environment “two-hit” model .hepatic fat accumulation .hepatic oxidative stressSteatosis
NASH
HEMOCHROMATOSIS.excessive accumulation of body iron, mostly in liver & pancreas .types -primary -secondary (hemosiderosis) .repeated blood transfusions .increased intestinal absorption of iron
primary (hereditary) hemochromatosis
.autosomal recessive, due to excessive intestinal absorption of iron.diagnosed at 5th decade of life
.males predominate by 5:1 to 7:1
.fully developed cases exhibit
-micronodular cirrhosis>hepatocellular carcinoma
-diabetes mellitus
-skin pigmentation
.pathogenesis -excessive iron is toxic to tissues through .lipid peroxidation via free radicals .stimulation of collagen via activation of stellate cells .interaction of reactive oxygen species & iron with DNA>lethal cell injury or hepatocellular carcinoma
Hemochromatosis
Hemochromatosis, Prussian blue stain
WILSON DISEASE.autosomal-recessive characterized by deficiency in ATP7B enzyme leading to -decrease in copper transport into bile -impairment of copper incorporation into ceruloplasmin -inhibition of ceruloplasmin secretion into the blood -accumulation of toxic levels of copper in .liver, (steatohepatitis, necrosis, cirrhosis) .brain, (damage to basal ganglia) .eye, (Kayser-Fleischer ring)
.clinical features -rare before the age of 6 years -acute or chronic liver disease -neuropsychiatric manifestations.diagnosis -biochemical changes .decrease in serum ceruloplasmin .increase in hepatic copper content (sensitive & specific test) .increase urinary excretion of copper (most specific screening test) -clinical (Kayser-Fleischer ring)
ALPHA-1 ANTITRYPIN DEFICIENCY.autosomal-recessive disorder .pathogenesis -accumulation of α1AT in endoplasmic reticulum leads to .autophagy .mitochondrial dysfunction .inflammation & hepatocyte damage .morphology -hepatocytes show (fatty change, hyaline cytoplasmic inclusions, Mallory bodies)
.clinical features -only 10%-15% of affected individuals have overt clinical features due to presence of .other genetic factors .environmental factors -in neonates .hepatitis & jaundice -in adolescence .hepatitis>recovery, or>cirrhosis -in adults .cirrhosis .liver cell carcinoma in 2%-3%
α1-antitrypsin deficiency, PAS stain
α1-antitrypsin deficiency, EM showing dilatation of endoplasmic reticulum
Intrahepatic Biliary Tract Disease
SECODARY BILIARY CIRRHOSIS .prolonged obstruction of extrahepatic biliary tree .causes -in adults (cholelithiasis, malignancies, surgical strictures) -in children (cystic fibrosis, congenital anomalies of biliary tree).morphology -inflammation>periportal fibrosis> cirrhosisSecodary biliary cirrhosis
PRIMARY BILIARY CIRRHOSIS .autoimmune, chronic, progressive, & often fatal cholestatic liver disease of middle-aged women .morphology -destruction of intra-hepatic bile ducts -portal inflammation & scarring -cirrhosis -hepatocellular carcinoma .presence in 90% of patients circulating antimitochondrial antibodies to bile ducts epithelial cells
Primary biliary cirrhosis, periductal inflammation
PRIMARY SCLEROSING CHOLANGITIS
.inflammation & obliterative fibrosis of intra- & extra-hepatic bile ducts.occurs in the 3rd through 5th decades of life, & males predominate by 2:1
.pathogenesis
-T cells activated in gut mucosa recognize a bile duct antigen that cross- reacts with gut antigens or enteric bacteria or bacterial products
-antibodies found include (anti-smooth muscle, anti-nuclear, rheumatoid factor, & p-ANCA)
.morphology -cholangitis>progressive obliteration & atrophy of bile ducts>scars>cirrhosis -surviving ducts become ectatic.clinical features -asymptomatic patients with persistent elevation of serum alkaline phosphatase -progressive fatigue, pruritus, & jaundice -late outcomes .hepatocellular carcinoma .cholangiocarcinoma (7%) .chronic pancreatitis
Primary sclerosing cholangitis, periductal fibrosis
Tumors And Tumor-Like Lesions
.presentation-epigastric fullness & discomfort
-detected by
.routine physical examination
.radiographic studies
NODULAR HYPERPLASIAS .focal nodular hyperplasia (solitary).nodular regenerative hyperplasia (numerous)common factor in both lesions is focal or diffuse obliteration of portal vein radicles with compensatory augmentation of arterial blood supply
Focal Nodular Hyperplasia.well-demarcated up to many centimeters in diameter most frequently in young to middle-aged adults.yellowish with central gray-white, depressed stellate scar from which fibrous septa radiate to the periphery.attributed to long-term use of anabolic hormones or of contraceptives
Focal nodular hyperplasia
Focal nodular hyperplasia
BENIGN NEOPLASMS Cavernous Hemangioma
Liver Cell Adenoma.occurs in young women on oral contraceptives.have clinical significance -mistaken for hepatocellular carcinoma -subcapsular adenomas may rupture, particularly during pregnancy>life- threatening intraperitoneal hemorrhage -rarely may transform into carcinoma
.morphology -grossly .well demarcated solitary or multiple nodules up to 30 cm in diameter .yellow-tan, & frequently bile-stained -histology .sheets & cords of hepatocytes .no portal tracts, instead, prominent solitary vessels are present
Liver cell adenoma
Liver cell adenoma
MALIGNANT NEOPLASMS
Hepatocellular carcinoma
Cholangiocarcinoma
Hepatoblastoma
Angiosarcoma
Hepatocellular Carcinoma .male:female is 3:1.age incidence 20-40 years.major etiological factors -viral infection (HBV,HCV) -chronic alcoholism -non-alcoholic steatohepatitis (NASH) -food contaminants (aflatoxins).pathogenesis -many factors interact (genetic, age, gender, chemicals, hormones, & nutrition) -repeated cell death & regeneration
.morphology -grossly (single mass, multifocal, diffuse) -histologically (differentiated, anaplastic)
Hepatocellular carcinoma
Hepatocellular carcinoma
.clinical features -non-specific -abdominal pain -abdominal fullness -abdominal mass.diagnosis -radiology -biopsy
.natural course -progressive enlargement>seriously disturbing hepatic function -metastasizes, to lungs & other sites -death occurs from .cachexia .G-I or esophageal variceal bleeding .liver failure .rupture of tumor with fatal hemorrhage -five year survival of large tumors is dismal (death within first 2 years)
Cholangiocarcinoma
.cancer of bile ducts
.risk factors
-primary sclerosing cholangitis
-congenital fibrocholecystic disease of biliary system
-previous exposure to Thorotrast
-chronic biliary infection by liver fluke
.morphology
-gross (single mass) -histology (glands formation without bile)
Cholangiocarcinoma
Cholangiocarcinoma
.diagnosis -radiology -biopsy.clinically is detected late as -obstruction to bile outflow -liver mass
Metastatic Tumors .far more common than primary ones .the most common primaries -breast -lung -colon.typically, multiple nodules are produced
LIVER TRANSPLANTION
.liver transplantation is aiming -to restore health -to improve survival .Posttransplantation survival at 5 years is 65%-78% -immunosuppressive therapy -surgical techniques
Types of donors
.non-heart beating donor (majority)-full size liver (adult)
-split liver
.left lateral segment (child)
.rest of liver (adult)
.living donor
-partial hepatectomy
.left lateral segment (child)
.right lobe (adult)
Who needs a liver transplant?
.acute/subacute liver failure.chronic liver failure
.hepatocellular carcinoma
.surgical gene therapy
Complications .immunosuppression -infection (local and systemic) -direct side effects on body organs -malignancy (late) .liver parenchyma -non-functioning liver -rejection -ischemic-reperfusion injury -anastomotic complications -bile leak -recurrence of disease (late)